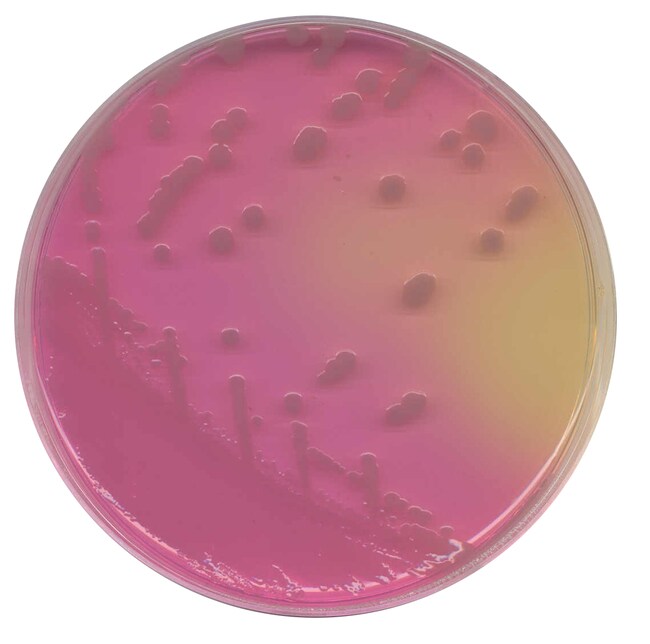
Oxoid™ 洋葱伯克霍尔德氏菌培养基

Search
Search
| 货号 | 描述 | 数量 | 形式 | 产量 |
|---|---|---|---|---|
| CM0995B | 洋葱博克霍尔德菌琼脂基础 | 500 g | 粉末 | 可以配制 13.7 升培养基 |
洋葱博克霍尔德菌(以前称为洋葱假单胞菌)是一种运动需氧氧化酶阳性革兰氏阴性杆菌,常见于液体容器和潮湿环境中。流动池宽 0.5-1.0 mm,长 5 mm。它是一种重要的条件致病菌,在囊性纤维化 (CF) 个体中引起肺部感染。CF 患者的分离株通常表现出多药耐药性,多达 20% 的定植个体将死于洋葱博克霍尔德菌综合征,这是一种与发热相关的坏死性肺炎,最终导致快速和致死性临床恶化1。
洋葱博克霍尔德菌琼脂基础基于最初由 Gilligan等人设计的 PC 培养基。其中 48 小时后洋葱博克霍尔德菌的生长优于麦康凯2。典型的洋葱博克霍尔德菌菌落为圆形,呈鼠尾草绿色,培养基在孵育期间从草绿色变为亮粉色。应进一步鉴别并确认所有菌落。
洋葱博克霍尔德菌最初从洋葱中分离出来,可长期存活,并在敌对环境中繁殖,如抗菌和消毒剂溶液、蒸馏水、漩涡浴、雾化器和市售包装的导尿管套件3。美国食品药品监督管理局 (FDA) 于 1998 年对亚利桑那州因无酒精漱口水受污染而爆发的疫情进行了调查,调查结果显示,该事件与制备产品用水的去电离程序有关4。在医院使用的许多非无菌产品中,微生物的数量可能较少。它已从各种水源中分离出来,由于其能够固定空气中的二氧化碳,因此可在含有氮源的蒸馏水中生长5。用醋酸溶液冲洗的吸引导管可降低洋葱博克霍尔德菌和其他假单胞菌传播的发生率。
部分国家或地区尚未销售赛默飞世尔科技的全部产品。详情请具体咨询。
Remel™ 和 Oxoid™ 产品现已归属 Thermo Scientific 品牌旗下,将强大的手动、半自动化以及全自动化检测产品与全面的培养基和诊断产品系列相结合,带来完整的端到端解决方案,能够快速交付您所需的产品以及您的实验室所倚重的高质量结果。
一般参考文献: